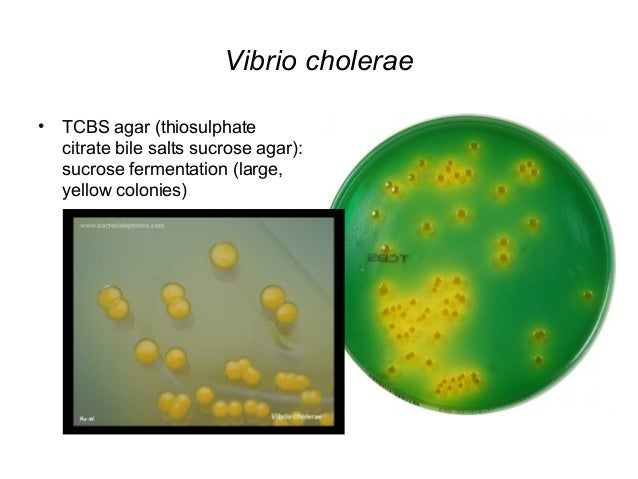
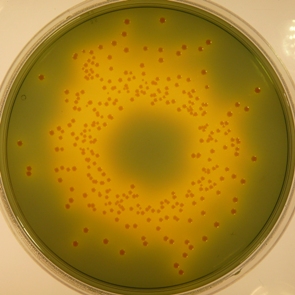

Щелочной агар среда
Щелочной агар среда 134 фотографий
Спасибо больше включи
Msfs 2026 версии
Улица промышленная чита
Лучшая система программирования
От головной боли рейтинг лучшие
Страны по продаже газа
Какой шрус лучше трипоидный или шариковый внутренний
Home digital school отзывы
Деревня кузнецовская
Рейтинг систем видеонаблюдения для дома